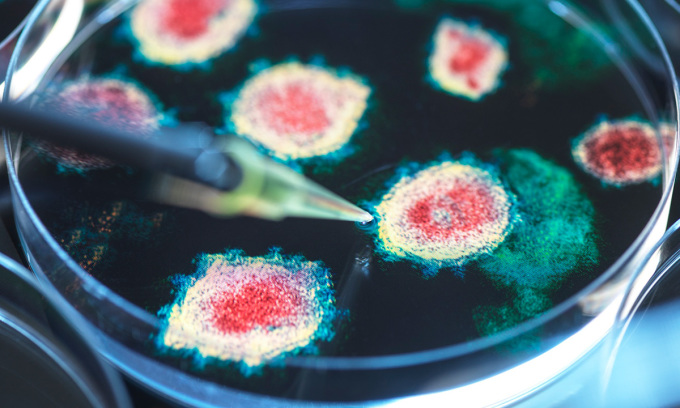

Một số bệnh truyền nhiễm lấy mạng phần lớn người mắc phải. Ảnh: Tek Image/Science Photo Library
Bệnh truyền nhiễm chiếm 3 trong 10 nguyên nhân gây tử vong hàng đầu theo Tổ chức Y tế Thế giới (WHO),gây ra hàng triệu ca tử vong mỗi năm trên toàn cầu. Theo Amesh Adalja,bác sĩ bệnh truyền nhiễm tại Trung tâm An ninh Y tế Johns Hopkins,gần như mọi bệnh truyền nhiễm từng có tỷ lệ tử vong 100% giờ có thể ngăn ngừa bằng vaccine hoặc điều trị nhờ y học hiện đại. Tuy nhiên,vẫn còn những bệnh truyền nhiễm gây tử vong mà nhân loại chưa thể giải quyết. Trong đó,một số bệnh luôn hoặc gần như luôn gây tử vong,số khác có tỷ lệ tử vong rất cao.
Ví dụ,viêm màng não do amip - hay nhiễm trùng amip "ăn não" - là bệnh nhiễm trùng hiếm gặp gần như luôn gây tử vong. Bệnh lan đến não qua mũi,thường xảy ra sau khi người bệnh ngâm mình trong nước ô nhiễm. Trong một số trường hợp hiếm,người bệnh được chữa trị thành công,nhưng các nhà khoa học vẫn đang tìm kiếm giải pháp tốt hơn.

Một dạng bệnh prion gọi là bệnh não xốp. Ảnh: UCSF
Một số bệnh hiếm khác vẫn còn là bí ẩn,ví dụ như các bệnh prion. Các bệnh này do protein gấp nếp sai trong não - gọi là prion - gây ra. Chúng khiến những protein khác cũng gấp nếp sai theo phản ứng dây chuyền,cuối cùng gây tổn thương não và tử vong.
Đa số trường hợp bệnh prion không được coi là truyền nhiễm. Chúng bắt nguồn từ những đột biến gene được thừa hưởng hoặc tự phát. Tuy nhiên,trong một số trường hợp hiếm,người ta có thể nhiễm bệnh sau khi ăn thịt nhiễm prion hoặc tiếp xúc với chúng trong các quy trình y tế,ví dụ bệnh Creutzfeldt-Jakob (vCJD) có thể mắc phải sau khi ăn thịt từ những con bò bị bệnh "bò điên",hay bệnh Kuru thường xảy ra trong cộng đồng người Fore ở Papua New Guinea.
"Prion đã được nghiên cứu suốt nhiều thập kỷ,nhưng tôi nghĩ mọi người vẫn đang cố gắng tìm ra nguyên nhân gốc rễ",Rodney E. Rohde,chuyên gia về bệnh truyền nhiễm tại Đại học Bang Texas,nói. Dù cực kỳ hiếm,các bệnh prion đều có một điểm chung: Khi đã nhiễm thì không có cách chữa trị,và cái chết thường đến vài tuần sau khi triệu chứng xuất hiện.
Điều gì khiến loại bệnh này dễ gây tử vong như vậy? Lịch sử tiến hóa của bệnh là một trong những lý do. Với một căn bệnh lây nhiễm cho vật chủ con người suốt hàng chục nghìn năm,cơ thể người đã nỗ lực xây dựng hàng rào chống lại nó,giúp tăng khả năng sống. Tuy nhiên,nếu con người là vật chủ ngẫu nhiên,hay vật chủ ngõ cụt - như trường hợp bệnh dại - thì bệnh không hướng tới giữ cho con người sống sót,vì con người không phải vật chủ chính. Trong những trường hợp như vậy,con người thường chưa phát triển được phản ứng miễn dịch phù hợp để chống trả mà không có sự trợ giúp y tế.
Ví dụ,bệnh dại gây ra phản ứng miễn dịch ở người,nhưng phản ứng này không đủ nhanh để đánh bại virus trước khi nó lan tới não và giết chết vật chủ. "Một số mầm bệnh có bản chất tồi tệ và hiểm ác hơn nhiều. Chúng ập tới hệ miễn dịch khiến cơ thể không thích ứng kịp",Rohde chia sẻ.
Thu Thảo (Theo Live Science)